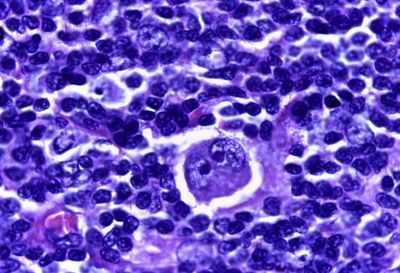
Лимфома Ходжкина

Болезнь Хожкина - частота, причины
Добавил пользователь Евгений Кузнецов Обновлено: 11.12.2025
Патология опухолевого характера, поражающая лимфатическую систему с ее узлами и сосудами. Главный вопрос, волнующий пациентов с лимфомой Ходжкина, — сколько живут с данным заболеванием? Патологию относят к числу злокачественных, при которых происходит постоянное деление пораженных клеток. Новые клеточные образования провоцируют сбои в функционировании лимфоузлов и всей соматической системы.
При выявлении заболевания на начальном этапе поражения узлов до начала миграции мутировавших клеток по организму вероятность успешного лечения и выживание пациента достаточно высока. Патология развивается медленно, с возникновением специфических симптомов. Благодаря своевременно начатому лечению при лимфогранулематозе прогноз более чем позитивный для 9 из 10 пациентов. Если же вовремя выявить заболевание не удалось, то на длительную устойчивую ремиссию могут надеяться лишь 7 человек из 10.
Причины заболевания
Патология отличается от других злокачественных поражений лимфоузлов наличием в них измененных и особых многоядерных клеток. Их называют клетками Штернберга и Ходжкина. Причины их появления в организмы до сих пор точно не установлены. Современная медицина лишь выдвигает версии, но опровергнуть или подтвердить их она не в состоянии.
Единственным доказанным фактом является развитие заболевания в результате поражения вирусом Эпштейна-Барр. Инфекция была обнаружена в многоядерных клетках новообразования. Ее влияние способствует активному клонированию измененных клеток, что приводит к их перерождению в опухолевые.
Уже в такой форме клетки начинают активно распространяться по организму.
Многие ученые склоняются к версии генной предрасположенности к развитию патологии. Предположение подкрепляется частыми случаями выявления заболевания у близнецов. Но работы по определению конкретного гена, запускающего болезнь Ходжкина, не принесли положительных результатов.
Рассматриваются и другие возможные причины патологии:
- Ослабление иммунитета. Развитие лимфогранулематоза определяется на фоне нарушений второго уровня защиты иммунной системы.
- Радиационное воздействие.
- Неблагоприятная экологическая обстановка.
- Длительный или регулярный контакт с растворителями органического происхождения, канцерогенными и химическими веществами.
- Наличие аутоиммунных патологий. Наибольшие опасения вызывает волчанка и ревматоидная форма артрита.
- Терапия с применением гормональных препаратов.
- Развитие лимфомы после лечения противораковыми лекарственными средствами.
Из списка была вычеркнута только версия о семейной предрасположенности к заболеванию. Но при этом вопрос о развитии патологии сразу у обоих однояйцевых близнецов остается необъясненным.
Виды и формы заболевания
Помимо классической формы, описанной Ходжкиным, современная медицина выделяет еще несколько видов заболевания:
- Классическая форма с доминированием лимфоцитов.
- Нодулярный склероз. Гистологическая форма с плотным разрастанием соединительнотканных структур.
- Нодулярная лимфома с доминированием лимфоцитов.
- Лимфома с нодулярным склерозом. Характерно разрушение лимфоузла фиброзными тяжами.
- Лимфома с лимфопенией. В области опухоли полностью отсутствуют здоровые лимфоциты. Здоровые ткани лимфоузла подменяются фиброзной тканью.
- Смешанно-клеточная патология. Наблюдается некроз лимфоузла. При исследовании опухоли обнаруживаются все лейкоцитарные клетки.
Для уточнения особенностей развития лимфомы Ходжкина специалист, основываясь на субъективных признаках заболевания, обязательно назначает пациенту ряд дополнительных инструментальных и лабораторных исследований. С их помощью удается определить специфику развития патологии.
Поставить при болезни Ходжкина прогноз, назначить терапию специалист может только после определения гистологического строения новообразования. Эффективность лечения и выживаемость больных во многом зависит от стадии патологии.
Стадии патологии
При лимфоме Ходжкина деление на стадии принято проводить, основываясь на тяжести течения болезни и широты зоны распространения опухолевых клеток. Всего существует 4 стадии:
- Болезнь протекает без симптомов. Ее обнаруживают случайно во время комплексного обследования. Опухолевые разрастания наблюдаются только в одной группе лимфоузлов.
- Опухолевый процесс обнаруживается в нескольких группах лимфоузлов. Гранулематозные соединения поражают ближайшие структуры.
- По обеим сторонам диафрагмы наблюдается обширное увеличение лимфоузлов. Гранулематозные включения поражают внутренние органы и ткани. В большинстве случаев у больных регистрируются множественные опухоли в печени и селезенке. Выживаемость пациентов в этом случае во многом зависит от выбранного курса терапии и чувствительности патологии к назначенным препаратам.
- Разрастание опухолевых образований нарушает функционирование многих структур организма. Статистика показывает, что на этом этапе у больных наблюдается значительный рост лимфоузлов. Отсутствие интенсивной терапии на этом этапе приводит к летальному исходу.
Выживаемость пациентов зависит то широты распространения опухолевых клеток. Чем меньше поражение организма, тем выше шанс на успешное лечение.
Симптоматика заболевания
Долгое время пациент может жить, не подозревая у себя лимфомы Ходжкина. Но внимание к различным изменениям в своем организме позволяет заметить симптомы патологии до ее перехода в третью или четвертую стадию. Специфическим признаком развития лимфомы Ходжкина считается лимфоденопатия. В этом случае у больного начинается усиленный рост лимфоузлов на фоне нормального самочувствия. Первыми изменяются подчелюстные лимфоузлы, затем паховые и подмышечные. Если они стали плотными и эластичными без тканевых спаек, приобрели подвижность, но остались безболезненными, рекомендуется немедленно обратиться за медицинской помощью.
Бездействие больного часто приводит к увеличению лимфоузлов до гигантских размеров.
Патологический рост негативно сказывается на функционировании всех прилегающих к лимфоузлам органов и тканей, что приводит к появлению симптомов в виде:
- Сухого кашля.
- Одышки, возникающей даже в состоянии покоя.
- Нарушение глотательной функции, спровоцированное сжатием пищеводного просвета. На первом этапе трудности вызывает проглатывание твердой пищи. В дальнейшем больному становится сложно проглатывать и жидкости.
- Отечности конечностей и увеличение печени, селезенки. Симптом сигнализирует о передавливании нижней и полой верхней вен. Нарушенное кровообращение способствует формированию дополнительных функциональных отклонений в организме.
- Нарушения пищеварения в виде диареи, запоров, вздутия.
- Нарушений двигательной функции конечностей.
Дальнейший рост опухоли провоцирует все более серьезное сдавливание окружающих тканей. К общим симптомам присоединяются и специфические.
Симптоматика поражения органов
Активное образование гранулем и опухолей приводит к серьезному поражению организма. У больного может наблюдаться:
- Гепатомегалия. Процесс разрастания гранулем способствует устранению здоровых клеток печени. Структурные поражения приводят к неспособности органа справляться со своими функциями.
- Спленомегалия. Увеличение тканей селезенки с их последующим уплотнением. Симптом часто проявляется при лимфоме 3 и 4 стадий.
- Нарушения дыхательной функции.
- Патологические изменения в костной структуре. Снижение прочности костей приводит к травме даже при незначительной нагрузке.
- Кожные патологии. У больных может наблюдаться зуд, жжение или болезненность некоторых участков кожи.
Системный характер поражения может выдавать себя длительной температурой, сопровождающейся ознобом и болью. При этом наблюдается обильное потоотделение при резком возвращении температуры в норму. Ее повышение наблюдается периодически. Истощенная иммунная система оказывается не в состоянии бороться с усталостью, стрессом. У пациента наблюдается сонливость, слабость, снижение концентрации.
На поздних стадиях лимфомы в результате функциональной недостаточности внутренних органов происходит стремительная потеря веса и мышечной массы. Истощение иммунитета делает организм уязвимым перед атаками различных инфекций. Если пациенту назначено химиотерапевтическое или радиотерапевтическое лечение, то вероятность частых инфекционных заболеваний многократно повышается.
Прогноз при лимфоме Ходжкина
Выживаемость при наличии заболевания зависит от его вида, стадии и вероятности рецидива. Абсолютное большинство пациентов, прошедших курс терапии, смогли полностью побороть патологию и добиться стойкой ремиссии. Подобный результат наблюдается в 90% случаев при лечении лимфомы 1 и 2 стадии. При этом используется комплексный подход, включающий радиотерапию или химиотерапию. Лечение, начатое на 3 или 4 стадии, обеспечивает длительную ремиссию в 75% случаев.
На эффективности лечения сказывается наличие сопутствующих заболеваний. Часто их присутствие ограничивает возможность применения некоторых противораковых препаратов.
Терапия занимает больше времени, а выживаемость пациента в этом случае оказывается под вопросом.
В случаях когда симптомы заболевания проявились только после его перехода в 4 стадию, лечение может оказаться неэффективным. Прогноз делается на основании клинической картины и вида патологии. Неэффективность терапии и летальный исход наблюдаются лишь в единичных случаях.
Для своевременного лечения лимфомы Ходжкина рекомендуется не отказываться от профилактического медицинского обследования, проводимого 1 раз в год. Заболевание на первых этапах протекает бессимптомно, что позволяет ему оставаться незамеченным длительное время. Во избежание развития тяжелых нарушений в организме, вызванных ростом лимфоузлов, рекомендуется не игнорировать появление первых признаков ослабления иммунитета и своевременно обращаться за медицинской помощью.
Заболевание лимфомой Ходжкина
Лимфома Ходжкина — это онкологическое заболевание, характеризующееся диссеминированным или локализированным стремительным размножением клеток лимфоретикулярной системы. В медицинской практике эта патология получила название лимфогранулематоза (ЛГМ).
В международной классификации болезней эта патология имеет коды по МКБ-10 С81-С81.9. В группу риска его развития входят люди от 15 до 35 лет. Следующий пик приходится на тех, кто перешагнул 50-летний возрастной рубеж. ЛГМ — это заболевание, которое ранее считалось неизлечимым, но сейчас при своевременном выявлении и начале терапии может быть устранено полностью.
Что это такое лимфома Ходжкина
В организме человека в результате деления клеток ежеминутно из-за неправильного взаимодействия нуклеозидов в молекулах ДНК формируются потенциально раковые клетки. В норме имеющиеся мутации делают их нежизнеспособными, что запускает процесс их отмирания, поэтому дальнейшее деление пораженной клетки не происходит и злокачественное образование не формируется.

Болезнь Ходжкина, или лимфогранулематоз, подтверждается, когда выявляются особые переродившиеся клетки Рид-Березовского-Штернберга. Изначально лишь в 1 лимфатическом узле начинает формироваться рак, онкология в этом случае носит локальный характер. Этот вариант патологии, в отличие от неходжкинской лимфомы, встречается реже. Происходит активация защитных механизмов организма и в пораженную область перемещается большое количество лейкоцитов. Это приводит к формированию плотного покрова вокруг опухолей и зарастанию их фиброзными тяжами.
Такие образования в пораженном лимфоузле формируют крупные гранулемы. Воспалительный процесс, который сопровождается появлением опухолей, приводит к тому, что лимфоузел стремительно увеличивается в размерах.
По мере прогрессирования заболевания метастазы опухоли приобретают способность распространяться.
Учитывая, что все лимфатические узлы располагаются возле жизненно важных органов, метастазы быстро распространяются на них. Это приводит к появлению множества вторичных гранулем не только в лимфатической системе, но и других тканях. Анализ крови при лимфоме Ходжкина позволяет выявить лимфоцитоз уже на ранних этапах развития патологии.
Причины и симптомы
Этиология появления этого патологического состояния еще не уточнена в полной мере. Исследователи выделяют несколько возможных причин возникновения такого типа онкологии, как болезнь Ходжкина. Особо выделяются вирусная, наследственная и иммунные теории появления этой патологии. Наиболее часто болезнь Ходжкина возникает у людей, перенесших в острой форме заражение вирусом Эпштейна-Барр и инфекционным мононуклеозом, ретровирусом и ВИЧ.
Согласно иммунологической теории возникновения этого патологического состояния, отмечается вероятность трансплацентарного переноса материнских лимфоцитов, которые в организме плода в дальнейшем запускают иммунопатологическую реакцию. Это наиболее вероятная причина развития лимфомы Ходжкина у детей и подростков.
Учитывая высокую частоту выявления случаев болезни Ходжкина у кровных родственников, выделяется его семейная форма. Уже выявлены гены, которые запускают процесс злокачественного перерождения тканей лимфатической системы.
Кроме того, велика вероятность развития этого патологического состояния при спонтанной мутации. К факторам, которые могли бы спровоцировать появление болезни Ходжкина, не обусловленного наследственной предрасположенностью, особенностями иммунной системы и вирусной нагрузкой, относятся:
- влияние ионизирующего излучения;
- отравление токсическими веществами;
- прием некоторых лекарственных препаратов;
- употребление пищи, богатой консервантами и канцерогенами.
У мужчин, которые работают на вредном производстве, в экологически неблагоприятных зонах и живут в крупных индустриальных городах, наиболее часто диагностируется болезнь Ходжкина неуточненная. Для того чтобы определить патологию, нередко достаточно оценки показателей, полученных при выполнении анализа крови на лимфогранулематоз. Вне зависимости от формы и вида течения патологического процесса у пациентов, страдающих болезнью Ходжкина, наблюдается появление следующих характерных симптомов:
- периодическая лихорадка до 39°C;
- общая слабость;
- снижение аппетита;
- кожный зуд;
- ночная потливость;
- потеря массы тела.
Степень выраженности этих симптомов во многом зависит от стадии развития злокачественной опухоли такого типа. По мере усугубления патологического процесса могут появляться интенсивные боли в лимфоузлах, ломота в костях и суставах, признаки дисфункции пораженных вторичными опухолями органов.
Существует несколько подходов классификации онкологии этого типа. В первую очередь болезнь Ходжкина подразделяют на локальный вид, сопровождающийся поражением одного или нескольких лимфатических узлов, а кроме того, генерализованный, при котором наблюдается гиперплазия, т. е. разрастание тканей в отдаленных органах, в том числе печени, селезенке, желудке, коже и легких.
В зависимости от скорости нарастания патологического процесса лимфогранулематоз может быть:
- острым, т. е. развивающимся в течение нескольких месяцев от начальной до терминальной степени;
- хроническим, для которого свойственно затяжное многолетнее течение, с чередованием периодов обострений и ремиссий.
Классическая лимфома Ходжкина подразделяется на 4 гистологических вида.
Самой редко встречающейся является гистологическая форма, сопровождающаяся лимфоидным истощением. В зависимости от морфологических особенностей данный вид болезни приводит к появлению многочисленных переродившихся клеток и интенсивному замещению здоровых тканей фиброзом.
Немного чаще встречается вариант патологии, характеризующийся лимфоидным преобладанием. В этом случае выявляется относительно небольшое количество клеток Рид-Березовского-Штейнберга и повышенное содержание B-лимфоцитов. Кроме того, могут присутствовать признаки сетчатого склероза.
Примерно в 25% случаев выявляется смешанно-клеточный вариант лимфомы. Этот гистологический вид патологии характеризуется появлением умеренного количества клеток Рид-Березовского-Штейнбега, но при этом инфильтрат является смешанным. Самый распространенный гистологический вид лимфомы Ходжкина — нодулярный склероз. На его долю приходится более 67% диагностированных случаев этой патологии.
Эта опухоль сопровождается появлением плотной оболочки из фиброзной ткани вокруг сформированных узелков из тканей Ходжкина
Для определения степени прогрессирования патологического процесса нередко используется классификация лимфомы Ходжкина по системе TNM, где буквы:
- Т — степень распространения имеющейся первичной опухоли;
- N — присутствие метастазов в расположенных рядом лимфоузлах и степень их выраженности;
- M — наличие отдаленных метастазов.
Эта классификация позволяет максимально уточнить распространенность онкологии.
Стадии
Согласно классификации TNM, выделяются 4 стадии лимфомы Ходжкина. Каждая имеет свои особенности. Первую стадию патологического процесса принято подразделять на подстадии I и IE. В этот период первичная опухоль прощупывается в 1 лимфатическом узле, вилочковой железе или селезенке. Несмотря на то, что при исследованиях уже могут быть выявлены признаки онкологии, болевых ощущений и проявлений общей интоксикации еще не наблюдаются
Течение 2 стадии патологического процесса подразделяется на подстадии II и IIE. При подстадии II перерожденные клетки обнаруживаются в 2 лимфоузлах и более, но с одной стороны диафрагмы. При подстадии IIЕ атипичные клетки выявляются в 1 или более лимфатических узлах, а также близлежащих органах или тканях. При 2 стадии высоки шансы на полное излечение при отсутствии факторов риска, к которым относятся:
- появление опухоли в груди до 10 см;
- сформированное образование в лимфатическом узле;
- критическое увеличение скорости оседания эритроцитов;
- более 3 пораженных лимфоузлов;
- развитие выраженных признаков общей интоксикации.
Болезнь Ходжкина 3 стадии подразделяется на 3 подстадии. Для этого периода развития патологического процесса характерно поражение лимфатической системы и располагающихся рядом с узлами тканей и органов с обеих сторон диафрагмы. Имеются яркие признаки поражения селезенки и общей интоксикации организма.
Лимфома Ходжкина 4 стадии характеризуется началом метастазирования не только в близлежащие к лимфоузлам органы, но и отдаленные. На стадии патологического процесса атипичные клетки обнаруживаются в цереброспинальной жидкости, печени, костном мозге, легких и т.д.
Диагностика заболевания
Особую роль в постановке диагноза играют инструментальные методы диагностики. Для определения распространения патологии при лимфоме Ходжкина нередко выполняется снимок — рентген грудной клетки. Это позволяет выявить увеличенные лимфоузлы. При диагностике этой патологии у беременных данный метод диагностики не используется, так как это может нанести вред развивающемуся плоду.
Для уточнения морфологического строения опухолей назначается биопсия, лапароскопия или торакоскопия для забора тканей для дальнейшего гистологического исследования. Может быть показана спленэктомия, т. е. операция по удалению селезенки. Чтобы диагностировать лимфому Ходжкина и степень распространения патологического процесса, назначается проведение таких исследований, как:
- УЗИ;
- компьютерная томография;
- пункция костного мозга;
- сцинтиграфия скелета;
- радионуклидное сканирование;
- контрастная ангиография;
- лимфосцинтиграфия;
- МРТ.
Необходимо дифференцировать лимфогранулематоз от лимфаденитов, развивающихся при токсоплазмозе, туберкулезе, бруцеллезе, ангине, краснухе, гриппе, сепсисе и СПИДе. Кроме того, необходимо исключить метастазы других видов рака, неходжкинские лимфомы и саркоидоз.
Лечение
После того как будет подтвержден диагноз лимфомы Ходжкина, назначается комплексная терапия. Для устранения патологии применяется медикаментозная, хирургическая и радиотерапия. Сочетание средств лечения позволяет добиться полной ремиссии. В редких случаях при поражении тканей костного мозга назначается его трансплантация. Это метод нередко используется при лечении детей, страдающих болезнью Ходжкина.
Лучевая терапия
Радиотерапия является ведущим методом лечения болезни Ходжкина, так как клетки Рид-Березовского-Штернберга чрезвычайно чувствительны к воздействию гамма-лучей, поэтому быстро отмирают при таком воздействии. Существует несколько видов лучевой терапии. Наиболее часто при лечении болезни Ходжкина используется радикальное мантиевидное облучение.
Курс начинают вне зависимости от того, на какой стадии была выявлена патология. При 1 и 2 стадиях заболевания этого достаточно для достижения выраженной ремиссии. При 4 стадии болезни Ходжкина целесообразно дополнять лучевую терапию медикаментозной. Операции используются в качестве полиативного метода терапии и служат для улучшения общего состояния.
Химиотерапия
Главной целью этого метода болезни Ходжкина является остановка деления опухолевых клеток. Химиотерапия может эффективно применяться на всех стадиях патологического процесса, но используется в сочетании с радиотерапией. Продолжительность курса химиотерапии при лимфоме составляет от 14 до 30 дней. Для устранения этого патологического состояния нередко применяются:
- Адриамицин.
- Блеомицин.
- Винбластин.
- Дакарбазин.
- Этопозид.
- Циклофосфан.
- Винкристин.
- Прокарбазин.
- Преднизолон.
- Цисплатин.
- Цитарабин
- Дексаметазон.
В большинстве случаев для купирования проявлений болезни Ходжкина используется комбинация этих препаратов.
Народные методы
Различные травы и составы из природных компонентов могут быть использованы только в качестве дополнения к традиционным методам терапии. Улучшить состояние при болезни Ходжкина может настойка из аконита.
Для ее приготовления нужно 50 г порошка корня этого растения залить ½ л водки. Настаивать средство нужно на протяжении 2 недель. Готовую настойку следует принимать по нарастающему методу, начиная с 1 капли 3 раза в день. Постепенно нужно довести дозировку до 10 капель 3 раза в день. После этого дозу следует постепенно снижать.
Настойку нужно запивать большим количеством воды.
Кроме того, для лечения болезни Ходжкина рекомендуется принимать спиртовую настойку конского каштана. Для приготовления этого средства нужно примерно 40 г растительного сырья залить ½ л водки и настаивать 2 недели. Принимать средство необходимо по 25 капель в сутки. Настойку нужно запивать большим количеством воды.
Питание
Специальная диета при лимфоме Ходжкина позволяет улучшить общее состояние, особенно после проведенной химиотерапии. В рацион при болезни Ходжкина обязательно нужно вводить молочные продукты. Кроме того, улучшить работу кишечника и ускорить вывод токсинов может употребление свежих и термически обработанных овощей и фруктов. При лечении лимфомы предпочтение следует отдавать нежирным сортам рыбы и мяса. Из рациона необходимо исключить фастфуд и полуфабрикаты, газированные напитки и алкоголь, жареное, жирное, соленое и сладкое.
Прогноз
Сколько живут пациенты с лимфомой Ходжкина, зависит от того, на какой стадии патологического процесса было начато лечение. При направленной терапии 1 стадии лимфомы прогноз благоприятный. В 95% случае удается достигнуть полной ремиссии. Лечение можно проводить и щадящими методами для достижения выраженного результата.
Прогноз 2 стадии лимфомы Ходжкина относительно благоприятен. В этом случае 5-летняя выживаемость наблюдается у 90% больных, прошедших комплексную терапию. При 3 степени патологического процесса в ремиссию лимфому удается ввести более чем на 5 лет лишь у 65% пациентов. Менее благоприятным прогнозом отличается лимфогранулематоз 4 стадии. Лишь у 45% пациентов наблюдается 5-летняя выживаемость.
Осложнения
Лимфома Ходжкина и неходжкинская форма опасны своими осложнениями. Увеличение пораженных лимфатических узлов может стать причиной сдавливания окружающих тканей. При поражении узлов в области шеи возникает нарушение работы связок. Кроме того, нередко пациенты испытывают трудности с глотанием. Из-за распространения метастаз может развиваться:
- отек легких;
- сердечная недостаточность;
- дисфункция печени;
- отказ почек.
Поражение тканей кишечника нередко приводит к перфорации и развитию перитонита. При разрастании опухоли в спинном мозге может развиться поперечный паралич. Поражение метастазами органов половой системы нередко становится причиной бесплодия. При остром течении заболевания возможен летальный исход из-за полиорганной недостаточности.
Рецидив
Хроническая или рецидивирующая форма проявляется выраженным обострением при нарушении режима поддерживающей терапии. Кроме того, спровоцировать рецидив могут повышенные физические нагрузки и беременность.
Обострение лимфомы Ходжкина нередко возникает на фоне сильнейших эмоциональных переживаний. Для снижения риска развития рецидивов пациентам необходимо наблюдаться у онколога или гематолога. Раннее выявление обострения позволяет более легкими методами подавить развивающийся онкологический процесс.
Реабилитация
Лучевая и химиотерапия, применяющиеся при лечении болезни Ходжкина, негативным образом отражаются на общем состоянии здоровья человека. Период реабилитации крайне важен, так как если восстановление пройдет эффективно, снизится риск рецидива болезни. На протяжении не менее 6 месяцев после завершения терапии необходимо придерживаться щадящей диеты.
Обязательно нужно нормализовать режим работы и отдыха, уделяя ночному сну не менее 9 часов. Кроме того, для восстановления здоровья пациентам рекомендуется выполнять специальную гимнастику. Большую пользу может принести курс массажа и посещение бассейна. В восстановительный период рекомендуется санаторно-курортное лечение.
Симптомы заболевания лимфомой Ходжкина
Лимфома Ходжкина, симптомы которой бывают как общими, так и специфическими, представляет собой онкологическое заболевание лимфатической системы, при котором на ранних стадиях поражается одна лимфатическая зона. У мужчин обнаруживается чаще, чем у женщин, наиболее подвержены этому заболеванию молодые люди 15-40 лет.
Причины возникновения
Точные причины возникновения лимфогранулематоза этой формы не установлены.

К факторам, повышающим риск развития злокачественной опухоли лимфатической зоны, относят:
- Вирусные инфекции. Свою роль в развитии заболевания играет вирус Эпштейна-Барр, который может привести к появлению мутаций и иных нарушений на генном уровне.
- Проживание в неблагоприятных условиях.
- Радиационное облучение.
- Генетическая предрасположенность. Считается, что риск возникновения лимфомы Ходжкина повышается, если подобное заболевание имелось у ближайших родственников. Этот факт пока не получил официального подтверждения.
- Хроническое отравление организма канцерогенами, пестицидами, гербицидами и органическими растворителями.
- Прием гормональных и химиотерапевтических препаратов, используемых для лечения иных форм рака.
- Наличие аутоиммунных патологий. Лимфома Ходжкина может развиться на фоне ревматоидного артрита или системной красной волчанки.
Симптомы лимфогранулематоза
На вопрос, что такое лимфома Ходжкина, можно ответить так: лимфома — это злокачественная опухоль лимфатической системы, имеющая следующие симптомы:
- Увеличение лимфоузлов. На ранних стадиях в патологический процесс вовлекается одна область, например, подмышечная, паховая или шейная. Лимфоузлы имеют эластичную консистенцию и высокую подвижность. По мере развития болезни Ходжкина они разрастаются, образуя крупные конгломераты.
- Проблемы с дыханием, синюшность кожных покровов и кашель. Эти симптомы характерны для поражения метастазами тканей легких или плевры.
- Боли и чувство тяжести в животе. Возникают при появлении клеток опухоли в печени, селезенке или кишечнике.
- Признаки анемии. Появляются при поражении костного мозга.
- Боли в костях.
- Симптомы интоксикации организма. Уже на ранних стадиях заболевания пациент начинает ощущать общую слабость, развивается лихорадочный синдром, усиливается потоотделение, снижается вес. Лихорадка у взрослых имеет волнообразное течение — на фоне кратковременного повышения температуры возникает озноб и потливость, после чего состояние улучшается.
- Появление рассеянных инфильтратов в легких, скопление выпота в плевральной полости.
- Увеличение печени, сопровождающееся повышением активности АЛТ и АСТ и снижением уровня альбумина.
- Поражение подслизистого слоя желудка и кишечника. Развивается при появлении вторичных очагов в пищеварительной системе на поздних стадиях лимфомы. Не сопровождается изъязвлением стенок органов.
- Выраженные неврологические нарушения. Возникают при появлении вторичных опухолевых новообразований в оболочках спинного мозга.
- Кожная сыпь. Обнаруживается у 30% заболевших, сопровождается сильным зудом. На фоне постоянного присутствия неприятных ощущений снижается аппетит, развиваются психические расстройства.
Признаки лимфомы Ходжкина на 4 стадии зависят от того, какие органы были поражены метастазами.
Стадии лимфомы
В соответствии с размерами и распространенностью выделяют следующие стадии развития опухоли лимфатической системы:
- Первая — характеризуется наличием ограниченного пределами лимфоузла новообразования или поражением одной области.
- Вторая — на данном этапе раковые клетки распространяются на 2 и более групп лимфоузлов, находящихся на одной стороне тела.
- Третья — процесс распространяется на несколько отделов лимфатической системы по обеим сторонам, поражается один экстралимфатический орган.
- Четвертая — раковые клетки обнаруживаются во всех лимфоузлах и в нескольких внутренних органах. Обнаруживаются диффузные поражения.
Диагностика
Выявление лимфомы Ходжкина, которая на ранних стадиях может никак не проявляться, осуществляется в несколько этапов. В первую очередь применяют следующие методики:
- анализ имеющихся у пациента симптомов;
- определение болевых зон в пораженных областях;
- отслеживание динамики увеличения лимфатических узлов;
- пальпация всех периферических отделов лимфатической системы;
- осмотр носоглотки;
- диагностическое хирургическое вмешательство по удалению увеличенного лимфоузла без нарушения его целостности.
Предварительный диагноз лимфома ставится только после проведения гистологического исследования. Обязательным является описание диагностических и сопровождающих клеток. В противном случае диагноз считается сомнительным. Дальнейшее обследование пациента включает:
- УЗИ периферических отделов лимфатической системы, органов малого таза и брюшной полости. Используется для выявления вторичных очагов поражения.
- КТ грудной клетки и шейной области.
- Остеосцинтиграфия. Используется для определения наличия или отсутствия метастазов в костях.
- Рентгенография. Назначается в случае выявления изменений на сцинтиграмме.
- Клинический анализ крови. Определяется группа и резус-фактор, количество лейкоцитов, тромбоцитов и эритроцитов, уровень гемоглобина и СОЭ.
- Биохимический анализ крови. Помогает обнаружить изменение уровня общего белка, мочевины, креатинина и печеночных ферментов.
- Анализ крови на гормоны щитовидной железы. Назначается в случае поражения шейных лимфоузлов.
- Пункция костного мозга с последующим цитологическим исследованием.
- Сцинтиграфия с применением контрастного вещества.
При постановке окончательного диагноза указывают стадию заболевания, наличие массивных зон поражения и метастатических очагов во внутренних органах.
Лечение лимфомы Ходжкина
Лечение лимфомы Ходжкина эффективно в большинстве случаев. Методы, входящие в состав первых программ лечения:
- Облучение, радиотерапия являются важной частью лечения злокачественных новообразований лимфатической системы. Специализированные лучевые программы обеспечивают высокую эффективность лечения на ранних стадиях.
- Химиотерапия. В состав лекарств от лимфомы входят цитостатические вещества, подавляющие деление раковых клеток. Подобный способ препятствует распространению опухоли в организме, устраняет симптомы заболевания.
- Трансплантация костного мозга. Единственный метод, способный полностью избавить пациента от лимфомы Ходжкина. Предварительно проводится несколько курсов химии, подавляющий активность всех очагов поражения. После этого подсаживают костный мозг или стволовые клетки. Через несколько дней трансплантат приживается и кроветворная система начинает функционировать в нормальном режиме.
- Лечение народными средствами. Важной роли в избавлении от лимфомы Ходжкина не играет, направлено на улучшение общего состояния организма, ослабленного облучением и химиотерапией.
Протокол включает введение четырех и более различных химиотерапевтических препаратов. Их подают через катетер, устанавливаемый в подключичную вену. Каждое средство по-своему воздействует на раковые клетки, совместное применение нескольких химиопрепаратов существенно повышает эффективность лечения.
Курс высокодозной химиотерапии при лимфоме Ходжкина включает следующие препараты:
- Винбластин;
- Винкристин;
- Преднизолон;
- Циклофосфан;
- Дакарбазин;
- Рубомицин;
- Блеомицин;
- Доксорубицин;
- Этопозид.
На ранних стадиях лимфомы Ходжкина назначают 2 курса химиотерапии, которые длятся несколько недель. Если пациент входит в группу высокого риска, требуется не менее 4 циклов. При лимфоме 3-4 стадии показано проведение 6-8 курсов химиотерапии.
Представляет собой воздействие высокоэнергетических лучей на злокачественные новообразования, риск повреждения здоровых клеток при этом оценивается как минимальный. Облучают пораженные лимфоузлы и окружающие их ткани. Лучевая терапия при лимфоме Ходжкина чаще всего применяется в сочетании с приемом цитостатиков. В качестве самостоятельного терапевтического способа может быть использована только на 1 стадии. Курс лечения длится 14-20 дней.
Лечение детей
Для устранения лимфомы Ходжкина у детей применяют следующие методы лечения:
- Пересадку костного мозга. Устраняет негативное влияние заболевания на функции кроветворной системы. Чаще всего производится аутологичная трансплантация.
- Хирургическое вмешательство. Эффективно только на ранних стадиях заболевания, представляет собой удаление пораженного лимфоузла. Выздоровление наблюдается в 75% случаев лимфомы 1 стадии.
- Химиотерапию. Число циклов, их интенсивность и виды препаратов зависят от заболевания и протокола, по которому лечат ребенка. Каждый блок занимает 2 недели. Наиболее эффективны при лимфоме у детей такие цитостатики, как Винкристин, Этопозид, Доксорубицин и Циклофосфамид.
- Радиотерапия. Проводится вслед за химиотерапией. Стандартная доза — 20 грей. При высокой скорости роста опухоли и сохранении ее размеров после двух курсов дозу повышают до 30 грей. Она достигается не за 1 сеанс, облучение производят небольшими порциями. Курс длится 2-3 недели, через каждые 5 дней делается перерыв.
Профилактика
Т. к. причины возникновения лимфомы Ходжкина точно не установлены, специфических мер профилактики не существует. Необходимо регулярно проходить обследование, своевременно устранять инфекционные заболевания. При появлении подозрительных симптомов обращаются к врачу. Не стоит забывать о соблюдении гигиенических правил, сбалансированном питании и занятиях спортом.
Диагностика и лечение лимфомы Ходжкина в Израиле
Лечение лимфомы Ходжкина в Израиле начинается с обследования, включающего:
- общий и биохимический анализы крови;
- исследование крови на онкомаркеры;
- анализ результатов проведенной ранее биопсии;
- повторное выполнение гистологического исследования, позволяющего обнаружить характерные для лимфомы клетки Березовского-Штейнберга;
- рентгенологическое исследование грудной клетки;
- КТ и МРТ брюшной области;
- выявление реактивных поражений лимфатической системы;
- диагностическую лапароскопию.
Лечение лимфомы подразумевает использование следующих препаратов и методик:
- Лучевой терапии. Назначается на 1-2 стадии заболевания.
- Химиотерапии. Показана при лимфогранулематозе 3-4 степени.
- Комбинированной терапии (прием цитостатиков и облучение). Отличаются высокой эффективностью, назначаются в большинстве случаев.
- Введения моноклональных антител. Этот высокоэффективный способ лечения злокачественных опухолей применяется в передовых клиниках Израиля.
- Трансплантации костного мозга. Необходима в случае рецидива заболевания.
Первые терапевтические курсы проводятся в стационарных условиях, в дальнейшем возможен переход к амбулаторному лечению лимфомы Ходжкина в Израиле.
Средняя 5-летняя выживаемость на 1 стадии приближается к 95%, полная ремиссия наступает в 90% случаев. Более 15 лет проживает 93% заболевших. На второй стадии средняя 5-летняя выживаемость — 88%. Рецидивы возникают у 35% пациентов. Высокие шансы на выздоровление имеются и в том случае, если лимфома обнаруживается на 3 стадии. После первичного рецидива выживает более половины пациентов, после вторичного — 1 из 10 человек. Однако и в таком случае имеются все шансы прожить более 10 лет.
Лимфогранулематоз
Лимфогранулематоз - злокачественная гиперплазия лимфоидной ткани, характерным признаком которой является образование гранулем с клетками Березовского-Штернберга. Для лимфогранулематоза специфично увеличение различных групп лимфатических узлов (чаще нижнечелюстных, надключичных, медиастинальных), увеличение селезенки, субфебрилитет, общая слабость, похудание. С целью верификации диагноза осуществляется биопсия лимфоузлов, диагностические операции (торакоскопия, лапароскопия), рентгенография грудной клетки, УЗИ, КТ, биопсия костного мозга. В лечебных целях при лимфогранулематозе проводится полихимиотерапия, облучение пораженных лимфоузлов, спленэктомия.



Общие сведения
Лимфогранулематоз (ЛГМ) - лимфопролиферативное заболевание, протекающее с образованием специфических полиморфно-клеточных гранулем в пораженных органах (лимфоузлах, селезенке и др.). По имени автора, впервые описавшего признаки заболевания и предложившего выделить его в самостоятельную форму, лимфогранулематоз также называют болезнью Ходжкина, или ходжкинской лимфомой. Средний показатель заболеваемости лимфогранулематозом составляет 2,2 случая на 100 тыс. населения. Среди заболевших преобладают молодые люди в возрасте 20-30 лет; второй пик заболеваемости приходится на возраст старше 60 лет. У мужчин болезнь Ходжкина развивается в 1,5-2 раза чаще, чем у женщин. В структуре гемобластозов лимфогранулематозу отводится втрое место по частоте возникновения после лейкемии.

Причины лимфогранулематоза
Этиология лимфогранулематоза до настоящего времени не выяснена. На сегодняшний день в числе основных рассматриваются вирусная, наследственная и иммунная теории генеза болезни Ходжкина, однако ни одна из них не может считаться исчерпывающей и общепризнанной. В пользу возможного вирусного происхождения лимфогранулематоза свидетельствует его частая корреляция с перенесенным инфекционным мононуклеозом и наличием антител к вирусу Эпштейна-Барр. По меньшей мере, в 20% исследуемых клеток Березовского-Штернберга обнаруживается генетический материал вируса Эпштейна-Барр, обладающего иммуносупрессивными свойствами. Также не исключается этиологическое влияние ретровирусов, в т. ч. ВИЧ.
На роль наследственных факторов указывает встречаемость семейной формы лимфогранулематоза и идентификация определенных генетических маркеров данной патологии. Согласно иммунологической теории, имеется вероятность трансплацентарного переноса материнских лимфоцитов в организм плода с последующим развитием иммунопатологической реакции. Не исключается этиологическое значение мутагенных факторов - токсических веществ, ионизирующего излучения, лекарственных препаратов и других в провоцировании лимфогранулематоза.
Предполагается, что развитие лимфогранулематоза становится возможным в условиях Т-клеточного иммунодефицита, о чем свидетельствует снижение всех звеньев клеточного иммунитета, нарушение соотношения Т-хелперов и Т-супрессоров. Главным морфологическим признаком злокачественной пролиферации при лимфогранулематозе (в отличие от неходжкинских лимфом и лимфолейкоза) служит присутствие в лимфатической ткани гигантских многоядерных клеток, получивших название клеток Березовского-Рид-Штернберга и их предстадий - одноядерных клеток Ходжкина. Кроме них опухолевый субстрат содержит поликлональные Т-лимфоциты, тканевые гистиоциты, плазматические клетки и эозинофилы. При лимфогранулематозе опухоль развивается уницентрически - из одного очага, чаще в шейных, надключичных, медиастинальных лимфатических узлах. Однако возможность последующего метастазирования обусловливает возникновение характерных изменений в легких, ЖКТ, почках, костном мозге.
Классификация лимфогранулематоза
В гематологии различают изолированную (локальную) форму лимфогранулематоза, при которой поражается одна группа лимфоузлов, и генерализованную - со злокачественной пролиферацией в селезенке, печени, желудке, легких, коже. По локализационному признаку выделяется периферическая, медиастинальная, легочная, абдоминальная, желудочно-кишечная, кожная, костная, нервная формы болезни Ходжкина.
В зависимости от скорости развития патологического процесса лимфогранулематоз может иметь острое течение (несколько месяцев от начальной до терминальной стадии) и хроническое течение (затяжное, многолетнее с чередованием циклов обострений и ремиссий).
На основании морфологического исследования опухоли и количественного соотношения различных клеточных элементов выделяют 4 гистологические формы лимфогранулематоза:
- лимфогистиоцитарную, или лимфоидное преобладание
- нодулярно-склеротическую, или нодулярный склероз
- смешанно-клеточную
- лимфоидное истощение
В основу клинической классификации лимфогранулематоза положен критерий распространенности опухолевого процесса; в соответствии с ним развитие болезни Ходжкина проходит 4 стадии:
I стадия (локальная) - поражена одна группа лимфоузлов (I) либо один экстралимфатический орган (IE).
II стадия (регионарная) - поражены две или более группы лимфатических узлов, расположенных с одной стороны диафрагмы (II) либо один экстралимфатический орган и его регионарные лимфоузлы (IIE).
III стадия (генерализованная) - пораженные лимфоузлы расположены с обеих сторон диафрагмы (III). Дополнительно может поражаться один экстралимфатический орган (IIIE), селезенка (IIIS) либо они вместе (IIIE + IIIS).
IV стадия (диссеминированная) - поражение затрагивает один или несколько экстралимфатических органов (легкие, плевру, костный мозг, печень, почки, ЖКТ и др.) с одновременным поражением лимфоузлов или без него.
Для обозначения наличия или отсутствия общих симптомов лимфогранулематоза на протяжении последних 6 месяцев (лихорадки, ночной потливости, похудания) к цифре, обозначающей стадию болезни, добавляются буквы А или В соответственно.
К числу характерных для лимфогранулематоза симптомокомплексов относятся интоксикация, увеличение лимфатических узлов и возникновение экстранодальных очагов. Часто заболевание начинается с неспецифических симптомов - периодической лихорадки с температурными пиками до 39°С, ночной потливости, слабости, похудания, кожного зуда.
Нередко первым «вестником» лимфогранулематоза служит увеличение доступных для пальпации лимфоузлов, которые больные обнаруживают у себя самостоятельно. Чаще это шейные, надключичные лимфатические узлы; реже - подмышечные, бедренные, паховые. Периферические лимфоузлы плотные, безболезненные, подвижные, не спаяны между собой, с кожей и окружающими тканями; обычно тянутся в виде цепочки.
У 15-20% пациентов лимфогранулематоз дебютирует с увеличения лимфоузлов средостения. При поражении медиастинальных лимфоузлов первыми клиническими признаками болезни Ходжкина могут служить дисфагия, сухой кашель, одышка, синдром ВПВ. Если опухолевый процесс затрагивает забрюшинные и мезентериальные лимфоузлы, возникают абдоминальные боли, отеки нижних конечностей.
Неходжкинские лимфомы ( Лимфосаркома )
Неходжкинские лимфомы - опухолевые заболевания лимфатической системы, представленные злокачественными B- и T-клеточными лимфомами. Первичный очаг может возникать в лимфатических узлах либо других органах и в дальнейшем метастазировать лимфогенным или гематогенным путем. Клиника лимфом характеризуется лимфаденопатией, симптомами поражения того или иного органа, лихорадочно-интоксикационным синдромом. Диагностика основывается на клинико-рентгенологических данных, результатах исследования гемограммы, биоптата лимфоузлов и костного мозга. Противоопухолевое лечение включает курсы полихимиотерапии и лучевой терапии.
МКБ-10



Неходжкинские лимфомы (НХЛ, лимфосаркомы) - различные по морфологии, клиническим признакам и течению злокачественные лимфопролиферативные опухоли, отличные по своим характеристикам от лимфомы Ходжкина (лимфогранулематоза). В зависимости от места возникновения первичного очага гемобластозы делятся на лейкозы (опухолевые поражения костного мозга) и лимфомы (опухоли лимфоидной ткани с первичной внекостномозговой локализацией). На основании отличительных морфологических признаков лимфомы, в свою очередь, подразделяются на ходжкинские и неходжкинские; к числу последних в гематологии относят В- и Т-клеточные лимфомы. Неходжкинские лимфомы встречаются во всех возрастных группах, однако более половины случаев лимфосарком диагностируется у лиц старше 60 лет. Средний показатель заболеваемости среди мужчин составляет 2-7 случая, среди женщин - 1-5 случаев на 100 000 населения. В течение последних лет прослеживается тенденция к прогрессирующему увеличению заболеваемости.

Причины
Этиология лимфосарком достоверно неизвестна. Более того, причины лимфом различных гистологических типов и локализаций существенно варьируются. В настоящее время правильнее говорить о факторах риска, повышающих вероятность развития лимфомы, которые на данный момент хорошо изучены. Влияние одних этиофакторов выражено значительно, вклад других в этиологию лимфом весьма несущественен. К такого рода неблагоприятным предпосылкам относятся:
- Инфекции. Наибольшим цитопатогенным эффектом на лимфоидные клетки обладает вирус иммунодефицита человека (ВИЧ), гепатита С, Т-лимфотропный вирус 1 типа. Доказана связь инфицирования вирусом Эпштейна-Барр с развитием лимфомы Беркитта. Известно, что инфекция Helicobacter pylori, ассоциированная с язвенной болезнью желудка, может вызывать развитие лимфомы той же локализации.
- Дефекты иммунитета. Риск возникновения лимфом повышается при врожденных и приобретенных иммунодефицитах (СПИДе, синдроме Вискотта-Олдрича, Луи-Бар, Х-сцепленном лимфопролиферативном синдроме и др.). У пациентов, получающих иммуносупрессивную терапию по поводу трансплантации костного мозга или органов, вероятность развития НХЛ увеличивается в 30-50 раз.
- Сопутствующие заболевания. Повышенный риск заболеваемости НХЛ отмечается среди пациентов с ревматоидным артритом, красной волчанкой, что может быть объяснено как иммунными нарушениями, так и использованием иммуносупрессивных препаратов для лечения данных состояний. Лимфома щитовидной железы обычно развивается на фоне аутоиммунного тиреоидита.
- Токсическое воздействие. Прослеживается причинно-следственная связь между лимфосаркомами и предшествующим контактом с химическими канцерогенами (бензолом, инсектицидами, гербицидами), УФ-излучением, проведением лучевой терапии по поводу онкологического заболевания. Прямое цитопатическое действие оказывают цитостатические препараты, применяемые для химиотерапии.
Патогенез
Патологический лимфогенез инициируется тем или иным онкогенным событием, вызывающим нарушение нормального клеточного цикла. В этом могут быть задействованы два механизма - активация онкогенов либо подавление опухолевых супрессоров (антионкогенов). Опухолевый клон при НХЛ в 90% случаев формируется из В-лимфоцитов, крайне редко - из Т-лимфоцитов, NK- клеток или недифференцированных клеток.
Для различных типов лимфом характерны определенные хромосомные транслокации, которые приводят к подавлению апоптоза, утрате контроля над пролиферацией и дифференцировкой лимфоцитов на любом этапе. Это сопровождается появлением клона бластных клеток в лимфатических органах. Лимфоузлы (периферические, медиастинальные, мезентериальные и др.) увеличиваются в размерах и могут нарушать функцию близлежащих органов. При инфильтрации костного мозга развивается цитопения. Разрастание и метастазирование опухолевой массы сопровождается кахексией.
Классификация
Лимфосаркомы, первично развивающиеся в лимфоузлах называются нодальными, в других органах (небной и глоточных миндалинах, слюнных железах, желудке, селезенке, кишечнике, головном мозге, легких, коже, щитовидной железе и др.) - экстранодальными. По структуре опухолевой ткани НХЛ делятся на фолликулярные (нодулярные) и диффузные. По темпам прогрессирования лимфомы классифицируются на индолентные (с медленным, относительно благоприятным течением), агрессивные и высоко агрессивные (с бурным развитием и генерализацией). При отсутствии лечения больные с индолентными лимфомами живут в среднем 7 - 10 лет, с агрессивными - от нескольких месяцев до 1,5-2 лет.
Современная классификация насчитывает свыше 30 различных видов лимфосарком. Большая часть опухолей (85%) происходит из В-лимфоцитов (В-клеточные лимфомы), остальные из Т-лимфоцитов (Т-клеточные лимфомы). Внутри этих групп существуют различные подтипы неходжкинских лимфом. Группа В-клеточных опухолей включает:
- диффузную В-крупноклеточную лимфому - самый распространенный гистологический тип лимфосарком (31%). Характеризуется агрессивным ростом, несмотря на это почти в половине случаев поддается полному излечению.
- фолликулярную лимфому - ее частота составляет 22% от числа НХЛ. Течение индолентное, однако возможна трансформация в агрессивную диффузную лимфому. Прогноз 5-летней выживаемости - 60-70%.
- мелкоклеточную лимфоцитарную лимфомуи хронический лимфоцитарный лейкоз - близкие типы НХЛ, на долю которых приходится 7% от их числа. Течение медленное, но плохо поддающееся терапии. Прогноз вариабелен: в одних случаях лимфосаркома развивается в течение 10 лет, в других - на определенном этапе превращается в быстрорастущую лимфому.
- лимфому из мантийных клеток- в структуре НХЛ составляет 6%. Пятилетний рубеж выживаемости преодолевает лишь 20% больных.
- В-клеточные лимфомы из клеток маргинальной зоны - делятся на экстранодальные (могут развиваться в желудке, щитовидной, слюнных, молочных железах), нодальные (развиваются в лимфоузлах), селезеночную (с локализацией в селезенке). Отличаются медленным локальным ростом; на ранних стадиях хорошо поддаются излечению.
- В-клеточную медиастинальную лимфому - встречается редко (в 2% случаев), однако в отличие от других типов поражает преимущественно молодых женщин 30-40 лет. В связи с быстрым ростом вызывает компрессию органов средостения; излечивается в 50% случаев.
- макроглобулинемию Вальденстрема (лимфоплазмоцитарную лимфому) - диагностируется у 1% больных с НХЛ. Характеризуется гиперпродукцией IgM опухолевыми клетками, что приводит к повышению вязкости крови, сосудистым тромбозам, разрывам капилляров. Может иметь как относительно доброкачественное (с выживаемостью до 20 лет), так и скоротечное развитие (с гибелью пациента в течение 1-2 лет).
- волосатоклеточный лейкоз- очень редкий тип лимфомы, встречающийся у лиц пожилого возраста. Течение опухоли медленное, не всегда требующее лечения.
- лимфому Беркитта - на ее долю приходится около 2% НХЛ. В 90% случаев опухоль поражает молодых мужчин до 30 лет. Рост лимфомы Беркитта агрессивный; интенсивная химиотерапия позволяет добиться излечение половины больных.
- лимфому центральной нервной системы - первичное поражение ЦНС может затрагивать головной или спинной мозг. Чаще ассоциируется с ВИЧ-инфекцией. Пятилетняя выживаемость составляет 30%.
Неходжкинские лимфомы Т-клеточного происхождения представлены:
- Т-лимфобластной лимфомой или лейкозом из клеток-предшественников - встречается с частотой 2%. Различаются между собой количеством бластных клеток в костном мозге: при 25% - как лейкоз. Диагностируется преимущественно у молодых людей, средний возраст заболевших - 25 лет. Худший прогноз имеет Т-лимфобластный лейкоз, показатель излечения при котором не превышает 20%.
- периферическими Т-клеточными лимфомами, включающими кожную лимфому (синдром Сезари, грибовидный микоз), ангиоиммунобластную лимфому, экстранодальную лимфому из естественных киллеров, лимфому с энтеропатией, панникулитоподобную лимфому подкожной клетчатки, крупноклеточную анапластическую лимфому. Течение большей части Т-клеточных лимфом быстрое, а исход неблагоприятный.

Симптомы
Варианты клинических проявлений НХЛ сильно варьируются в зависимости от локализации первичного очага, распространенности опухолевого процесса, гистологического типа опухоли и пр. Все проявления лимфосарком укладываются в три синдрома: лимфаденопатии, лихорадки и интоксикации, экстранодального поражения. В большинстве случаев первым признаком НХЛ служит увеличение периферических лимфоузлов. Вначале они остаются эластичными и подвижными, позднее сливаются в обширные конгломераты. Одновременно могут поражаться лимфоузлы одной или многих областей. При образовании свищевых ходов необходимо исключить актиномикоз и туберкулез.
Такие неспецифические симптомы лимфосарком, как лихорадка без очевидных причин, ночная потливость, потеря веса, астения в большинстве случаев указывают на генерализованный характер заболевания. Среди экстранодальных поражений доминируют неходжкинские лимфомы кольца Пирогова-Вальдейера, ЖКТ, головного мозга, реже поражаются молочная железа, кости, паренхима легких и др. органы. Лимфома носоглотки при эндоскопическом исследовании имеет вид опухоли бледно-розового цвета с бугристыми контурами. Часто прорастает верхнечелюстную и решетчатую пазуху, орбиту, вызывая затруднение носового дыхания, ринофонию, снижение слуха, экзофтальм.
Первичная лимфосаркома яичка может иметь гладкую или бугристую поверхность, эластическую или каменистую плотность. В некоторых случаях развивается отек мошонки, изъязвление кожи над опухолью, увеличение пахово-подвздошных лимфоузлов. Лимфомы яичка предрасположены к ранней диссеминации с поражением второго яичка, ЦНС и др.
Лимфома молочной железы при пальпации определяется как четкий опухолевый узел или диффузное уплотнение груди; втяжение соска нехарактерно. При поражении желудка клиническая картина напоминает рак желудка, сопровождаясь болями, тошнотой, потерей аппетита, снижением веса. Абдоминальные лимфосаркомы могут проявлять себя частичной или полной кишечной непроходимостью, перитонитом, синдромом мальабсорбции, болями в животе, асцитом. Лимфома кожи проявляется зудом, узелками и уплотнением красновато-багрового цвета. Первичное поражение ЦНС более характерно для больных СПИДом - течение лимфомы данной локализации сопровождаются очаговой или менингеальной симптоматикой.
Наличие значительной опухолевой массы может вызывать сдавление органов с развитием жизнеугрожащих состояний. При поражении медиастинальных лимфоузлов развивается компрессия пищевода и трахеи, синдром сдавления ВПВ. Увеличенные внутрибрюшные и забрюшинные лимфатические узлы могут вызвать явления кишечной непроходимости, лимфостаза в нижней половине туловища, механической желтухи, компрессии мочеточника. Прорастание стенок желудка или кишечника опасно возникновением кровотечения (в случае аррозии сосудов) или перитонита (при выходе содержимого в брюшную полость). Иммуносупрессия обусловливает подверженность пациентов инфекционным заболеваниям, представляющим угрозу для жизни. Для лимфом высокой степени злокачественности характерно раннее лимфогенное и гематогенное метастазирование в головной и спинной мозг, печень, кости.
Вопросы диагностики неходжкинских лимфом находятся в компетенции онкогематологов. Клиническими критериями лимфосаркомы служат увеличение одной или нескольких групп лимфоузлов, явления интоксикации, экстранодальные поражения. Для подтверждения предполагаемого диагноза необходимо проведение морфологической верификации опухоли и инструментальной диагностики:
- Исследование клеточного субстрата опухоли. Выполняются диагностические операции: пункционная или эксцизионная биопсия лимфоузлов, лапароскопия, торакоскопия, аспирационная пункция костного мозга с последующими иммуногистохимическими, цитологическими, цитогенетическими и другими исследованиями диагностического материала. Кроме диагностики, установление структуры НХЛ важно для выбора тактики лечения и определения прогноза.
- Методы визуализации. Увеличение медиастинальных и внутрибрюшных лимфоузлов обнаруживается с помощью УЗИ средостения, рентгенографии и КТ грудной клетки, брюшной полости. В алгоритм обследования по показаниям входят УЗИ лимфатических узлов, печени, селезенки, молочных желез, щитовидной железы, органов мошонки, гастроскопия. С целью стадирования опухоли проводится МРТ внутренних органов; в выявлении метастазов информативны лимфосцинтиграфия, сцинтиграфия костей.
- Лабораторная диагностика. Направлена на оценку факторов риска и функции внутренних органов при лимфомах различных локализаций. В группе риска производится определение ВИЧ-антигена, анти-HCV. Изменение периферической крови (лимфоцитоз) характерно для лейкемизации. Во всех случаях исследуется биохимический комплекс, включающий печеночные ферменты, ЛДГ, мочевую кислоту, креатинин и др. показатели. Своеобразным онкомаркером НХЛ может служить b2-микроглобулин.
Дифференцировать неходжкинские лимфомы приходится с лимфогранулематозом, метастатическим раком, лимфаденитами, возникающими при туляремии, бруцеллезе, сифилисе, туберкулезе, токсоплазмозе, инфекционном мононуклеозе, гриппе, СКВ и др. При лимфомах конкретных локализаций проводятся консультации профильных специалистов: оториноларинголога, гастроэнтеролога, маммолога и т.д.

Варианты лечения неходжкинских лимфом включают оперативный метод, лучевую терапию и химиотерапию. Выбор методики определяется морфологическим типом, распространенностью, локализацией опухоли, сохранностью и возрастом больного. В современной онкогематологии приняты протоколы лечения лимфосарком, базирующиеся на использовании:
- Химиотерапии. Наиболее часто лечение лимфом начинают с курса полихимиотерапии. Этот метод может являться самостоятельным или сочетаться с лучевой терапией. Комбинированная химиолучевая терапия позволяет достичь более длительных ремиссий. Лечение продолжается до достижения полной ремиссии, после чего необходимо проведение еще 2-3 консолидирующих курсов. Возможно включение в циклы лечения гормонотерапии.
- Хирургических вмешательств. Обычно применяется при изолированном поражении какого-либо органа, чаще - ЖКТ. По возможности операции носят радикальный характер - выполняются расширенные и комбинированные резекции. В запущенных случаях, при угрозе перфорации полых органов, кровотечения, непроходимости кишечника могут выполняться циторедуктивные вмешательства. Хирургическое лечение обязательно дополняется химиотерапией.
- Лучевой терапии. В качестве монотерапии лимфом применяется только при локализованных формах и низкой степени злокачественности опухоли. Кроме этого, облучение может быть использовано и в качестве паллиативного метода при невозможности проведения других вариантов лечения.
- Дополнительных схем лечения. Из альтернативных методов хорошо себя зарекомендовала иммунохимиотерапия с применением интерферона, моноклональных антител. С целью консолидации ремиссии применяется трансплантация аутологичного или аллогенного костного мозга и введение периферических стволовых клеток.
Прогноз и профилактика
Прогноз при неходжкинских лимфомах различен, зависит, главным образом, от гистологического типа опухоли и стадии выявления. При местнораспространенных формах долгосрочная выживаемость в среднем составляет 50-60%, при генерализованных - всего 10-15%. Неблагоприятными прогностическими факторами служат возраст старше 60 лет, III-IV стадии онкопроцесса, вовлечение костного мозга, наличие нескольких экстранодальных очагов. Вместе с тем, современные протоколы ПХТ во многих случаях позволяют добиться долгосрочной ремиссии. Профилактика лимфом коррелирует с известными причинами: рекомендуется избегать инфицирования цитопатогенными вирусами, токсических воздействий, чрезмерной инсоляции. При наличии факторов риска необходимо проходить регулярное обследование.
2. Эпидемиология и биология неходжкинских лимфом/ Хансон К.П., Имянитов Е.Н.// Практическая онкология. - 2004 - Т.5, №3.
4. Современные подходы к терапии неходжкинских лимфом/ Поддубная И. В.// Русский медицинский журнал. - 2011. - №22.
Читайте также:
